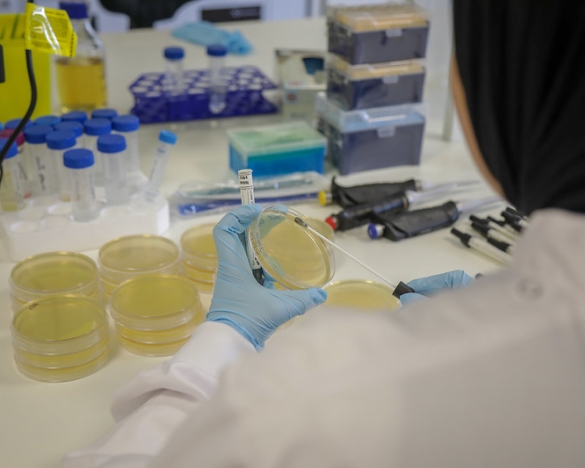

Research findings provide credible evidence that can be used for policymaking towards rational use of antimicrobials and effective control of antimicrobial resistance. To support efforts to implement and improve country-level surveillance of antimicrobial resistance, our researchers are collaborating with national governments to set up data collection systems on antimicrobial use.
Key activities
- Synthesize evidence on antimicrobial use and antimicrobial resistance to inform public policy and the development of credible, enforceable regulations that reduce antimicrobial use.
- Generate evidence to promote good practices in the governance, supply, use and disposal of agriculture-associated antimicrobials and identify incentives that facilitate their adoption.
- Engage agriculture and health policymakers and encourage integrated policy approaches in the context of the One Health approach.
- Pilot and evaluate approaches for surveillance antimicrobial resistance, antimicrobial use, presence of antimicrobials in the environment and antimicrobial treatment failure.
- Contribute to mapping of existing and projected future use of antimicrobials in the face of increasing intensification of farming systems.
- Provide evidence-based recommendations to support the implementation of antimicrobial stewardship programs.